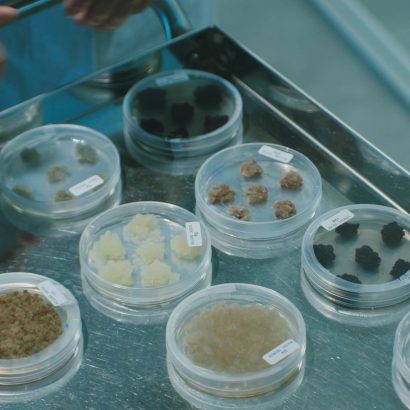

Category - Blog
Overnight under the microscope: the unique sensoriality of this formula
Blog
By Dr. Alessia Costantini, Researcher at UNIRED. What our skin feels when we apply a product as fascinating as Liftable Overnight is the result of the interaction between many ingredients that make up the carrier. In technical terms,…
LOXstem: biotechnological excellence Made in Italy
Blog
The excellence of Italian biotechnology becomes a key partner of MyCli in the development of Liftable Overnight Cream, through an active ingredient that has shown outstanding performance in optimizing the quality of dermal collagen and elastin. Created in…
The Lipopeptide that becomes Elastin: firmer skin
Blog
When we began developing Liftable Overnight, we consulted many of the leading companies specializing in cosmeceutical molecules with anti-gravity properties—ingredients designed to counteract dermal aging and the loss of supportive fibers. We wanted an innovative, reliable formula with…
A space carrier: the new hybrid and sustainable technology
Blog
The formula of Liftable Overnight Cream marks a new era in MyCli’s cosmeceutical development. Developed over more than two years in our research laboratories, this new anti-gravity cream from the Liftable line was designed to slowly release active…
“Vitamin C: The Best? It’s All About the Right Outfit!” – Dr. Claudia Simonetto
Blog
We’ve all grown up with the idea that orange juice isn’t just a delicious drink for its taste but also good for our health. And that this nice glass of orange juice should be drunk quickly, fast,fast! Over…
“Does Your Biological Age Match Your Chronological Age?” – Dr. Maria Vittoria Giatti
Blog
For some time now, we’ve realized that genetics alone cannot explain aging, as environmental factors also play a role in influencing the expression and activity of our genes, accelerating the aging process. This is the fascinating chapter of…
“HA-Plast Eye Contour: Why It’s Our Best-Seller” – Dr. Maria Cimmino
Blog
“A successful product always has a great formulation story to tell. In the case of our HA-Plast eye contour from the HA-Plast line, product development began by considering the needs of this delicate area of the face when…
“Exfoliants and Peeling in Ambulatory Care” – Dr. Rossella Sferrazza
Blog
From professional peeling to home exfoliation, there is a technical-scientific pathway offering complementary and synergistic benefits. Dr. Rossella Sferrazza, a plastic surgeon passionate about aesthetic medicine, introduces us to this world with a precise and clear reflection. The…
Vitamin C: Orange Is the New Black” – Dr. Gianni Baratto
Blog
Vitamin C: Here’s Why “Orange Is the New Black” The discovery of vitamin C dates back almost 90 years—89 to be precise. Historians of pharmacy describe two competing research teams racing to isolate the vitamin that had proven…
In Vitro Veritas
Blog
Unlock Active Renewing Concentrate and Skin Permeability: The Study The in vitro test demonstrating the increased penetration capability of a home cosmeceutical routine The goal of any cosmeceutical protocol is to achieve the best results, tailoring its effectiveness…